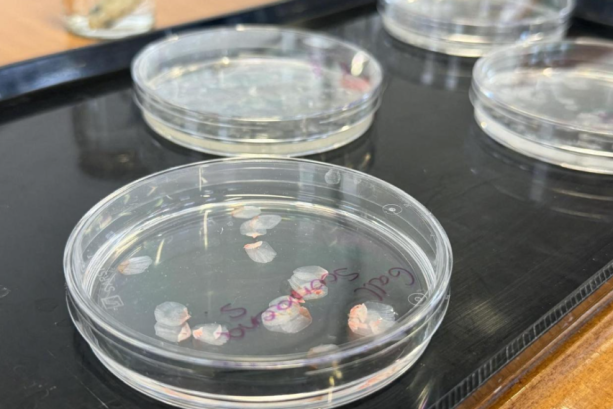

„YouTube“ тестира опција за оценување видеа како „AI ѓубре“! Корисниците се сомневаат дека целта е тренирање на вештачка интелигенција, а не заштита од неквалитетна содржина.
„YouTube“ започна да тестира нова функција која од гледачите бара да оценат дали видеото што штотуку го изгледале е „AI ѓубре“, колоквијален термин за неквалитетна содржина генерирана со вештачка интелигенција. По гледањето, на дел од корисниците во мобилната апликација им се прикажува анкета со прашањето: „Дали имате чувство дека ова е AI ѓубре?“ или „Колку ова видео делува како неквалитетна AI содржина?“. Одговорите се понудени на скала од пет степени, од „Воопшто не“ до „Екстремно“. Овој потег претставува обид на платформата да се справи со растечкиот бран од повторлива и често бесмислена содржина што масовно се произведува со помош на AI алатки со цел брза заработка од реклами. Иако функцијата моментално се тестира на мал број корисници, таа сигнализира дека „YouTube“ бара нови начини за филтрирање на содржина што го нарушува корисничкото искуство.

Поплава од бесмислена содржина на платформата
Проблемот со т.н. „AI ѓубре“ стана огромен. Според едно неодамнешно истражување, дури 21 отсто од видеата препорачани на целосно нови кориснички профили спаѓаат во оваа категорија, додека една третина може да се класифицира како „brainrot“ – поширок поим за повторлива содржина со ниска вредност. Друго истражување открило стотици канали кои објавуваат исклучиво ваков материјал, а заедно собрале повеќе од 63 милијарди прегледи и оствариле проценет годишен приход од над сто милиони долари. Оваа содржина често е насочена и кон најмладата публика. Извршниот директор на „YouTube“, Нил Мохан, во јануари 2026 година ја означи борбата против неквалитетната AI содржина како еден од главните приоритети на компанијата, нагласувајќи дека станува сè потешко да се разликува вистинска содржина од онаа генерирана со вештачка интелигенција.

Трет столб на одбрана или тренинг за понапредна AI?
Новиот систем за оценување е замислен како „трет столб на одбрана“, кој ги надополнува постојните автоматизирани системи и тимовите од човечки модератори кои тешко се справуваат со огромната количина нов материјал. Сепак, потегот веднаш предизвика скептицизам меѓу корисниците. На социјалните мрежи како „X“ брзо се прошири теорија дека „YouTube“ не ги користи овие податоци за да се бори против неквалитетна содржина, туку за да ги тренира своите AI модели да создаваат уште поубедливи и потешко препознатливи видеа.
Корисниците повлекоа паралели со претходни практики на технолошките гиганти. „Google“, сопственик на „YouTube“, со години ги користеше „reCAPTCHA“ тестовите – каде корисниците препознаваат објекти на слики – за бесплатно да ги тренира своите системи за препознавање слики. Сомнежите дополнително се зголемуваат поради фактот што и самиот „YouTube“ развива сопствени AI алатки кои им овозможуваат на креаторите да создаваат содржина преку едноставни текстуални команди.
Еден корисник на платформата „X“ ги сумираше стравовите на многумина: „YouTube“ не ве прашува дали ова е ’AI ѓубре‘ за да ве заштити. Ве користи за да го тренира својот следен AI за да произведува ѓубре толку добро што никогаш нема да ја забележите разликата. И ве натера да го правите тоа бесплатно.“

Нејасна иднина и загриженост кај креаторите
„YouTube“ сè уште официјално не објави како планира да ги користи собраните повратни информации. Аналитичарите претпоставуваат дека видеата кои често ќе бидат означувани како „AI ѓубре“ би можеле да бидат деградирани во алгоритмот за препораки, да ја изгубат можноста за монетизација или дури да бидат отстранети.
Овој пристап, сепак, предизвикува загриженост кај креаторите кои користат AI алатки на легитимен начин – за подобрување на квалитетот на видеата, автоматски превод или создавање визуелни ефекти. Постои страв дека субјективните оценки на гледачите би можеле неправедно да казнат висококвалитетна содржина само затоа што во нејзината изработка е користена вештачка интелигенција. Исто така, останува отворено прашањето за потенцијална злоупотреба на системот преку организирани кампањи за масовно пријавување содржини на конкурентски канали.